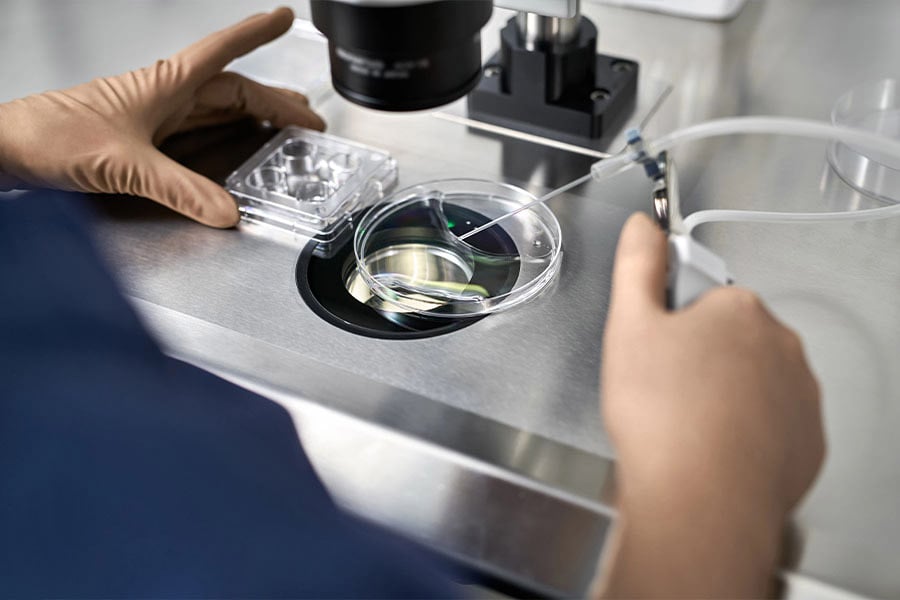
Инвитро, ин витро.

Инвитро – какво трябва да знаем?
Инвитро от латински (in vitro) означава “в стъкло”. Името говори, че този вид процедури се осъществяват извън живия организъм, или в епруветка в лабораторни условия. Открива се също и като “ин витро” по латинския модел.
За да се получи този тип изкуствено оплождане, от жената се събират яйцеклетки. След това се оплождат от сперматозоиди, които са взети от партньора на жената или от донор. Възможно е яйцеклетките също да са от донор поради различни причини.
След успешен контакт на сперматозоида и яйцеклетката оплодените клетки се пренасят в матката на бъдещата майка.
Инвитро оплождането има няколко най-общи стъпки:
- Прием на специални медикаменти от бъдещата майка за стимулиране на яйчниците и производство на зрели яйцеклетки.
- Изследвания с ултразвук и кръвни тестове, за да се определи най-подходящият момент за извличане на яйцеклетките
- Вземане на яйцеклетки. Прилага се фоликуларна пункция, при която зрелите яйцеклетки се извличат от яйчниците с помощта на тънка игла, насочвана чрез ултразвук.
- Оплождане на яйцеклетките със сперматозоиди от партньора. Извършва в контролирана лабораторна среда.
- Връщане на яйцеклетките в матката на бъдещата майка. Процесът се нарича ембриотрансфер. При него един или повече ембриони се прехвърлят през влагалището и маточната шийка в матката като се ползва тънък, мек катетър.
Разбира се, процедурата е много по-сложна от това и включва различни изследвания и тестове. Но това може да е първата насока, която да ни подготви за това какво да очакваме и в каква последователност ще се случва този процес.
Причини да изберем инвитро

Инвитро често се използва от двойки, при които жената е над 40-годишна възраст. Среща се обаче и при други възрастови групи поради различни здравословни причини, които може да направят естественото зачеване трудно или невъзможно. Това може да бъдат:
- Проблеми с фалопиевите тръби на жената. За да се пренесе естествено яйцеклетката от яйчника до матката и да се случи успешно оплождане от сперматозоид, фалопиевите тръби трябва да са здрави и в тях да няма блокажи.
- Проблеми с овулацията. Различни заболявания и здравословни състояния може да са причина за рядка или липсваща овулация. Без този процес яйцеклетката не може да бъде оплодена от сперматозоидите.
- Ендометриоза. Това е е хронично заболяване, при което тъкан, подобна на вътрешния слой на матката (ендометриум), расте извън матката. То има различни симптоми и признаци, като може да затрудни естественото зачеване, тъй като влияе на цялата репродуктивна система.
- Миоми на матката. Това са доброкачествени тумори, които се образуват в мускулния слой на матката. Състоянието може да затрудни закрепването на яйцеклетката към матката, което е основополагащо за развитието на ембрион от оплодената яйцеклетка.
- След предишна стерилизация. Някои жени се подлагат на операция за женска стерилизация, също познато като прекъсване на фалопиевите тръби. Тази процедура прави забременяването невъзможно. В тези случаи обаче зачеването с помощта на инвитро е възможно и може да е вариант за хора, които са променили решението си.
- При качествени и количествени проблеми на спермата. Инвитро се практикува и при здрави жени с мъже, които имат определени здравословни състояния. Възможно е в някои случаи като при ниско количество на качествени сперматозоиди да се наложи изкуствено оплождане с помощта на инвитро процедури.
- Необяснимо безплодие. За жалост, лекарите невинаги имат всички отговори за нашето здраве и състояние на организма. При някои двойки се наблюдава трудност при забременяване, без да може да се открие точна причина за това. В тези случаи инвитрото също е възможност за зачеване.
- Генетична обремененост. Някои хора се отказват от естественото зачеване поради наличието на генетична обремененост за различни тежки заболявания. По този начин те не предават заболяването на детето си и увеличават възможността то да расте здраво.
Както виждаме, причините да изберем инвитро оплождане може да са много и зависят изцяло от живота и желанията на бъдещите родители.
Как да се подготвим за инвитро оплождане?

По време на инвитро процедурите вашия лекар ще ви насочва през стъпките и етапите на този процес. Въпреки това може да се информирате преди започването, за да сте по-спокойни и да знаете какво ви очаква.
Има някои основни изследвания, които се правят на бъдещите родители. Като за начало се прави анализ на спермата и на качеството на женските яйцеклетки. Допълнително и двамата партньори преминават през тестове за някои заболявания като например ХИВ/СПИН.
Пациентката преминава през различни изследвания, които да разгледат матката и да подготвят лекаря за специфичната й анатомия. Състоянието на яйчниците и матката се проследява по време на процедурите.
Как да се подготви партньорът ни преди инвитро процедурата?
Не бива да забравяме, че пътят към това да бъдем родители се поема както от жената, така и от мъжа. Въпреки че инвитро процедурите се прилагат основно върху женското тяло, мъжката психика също усеща стреса и напрежението от процеса.
Проучвания показват, че мъжете често не усещат достатъчно подкрепа по време на тези процеси, а стигмата около изкуственото оплождане влияе силно и на тях. По-добро психическо здраве се наблюдава при мъже, които имат близки и семейство, които разбират проблемите и оказват подкрепа.
Често мъжете остават на заден план и дори не присъстват на срещите между лекарите и жената. Това може да ги накара да се чувстват сякаш не участват в процеса по забременяване и губят връзката с партньорката си. Важно е мъжете също да се информират за процедурата, за да може да подкрепят жената до себе си, но и да усещат своето присъствие в процеса.
Рискове и усложнения при инвитро

Възможно е да се появят определени нежелани ефекти вследствие на процедурите. Някои от тях са:
- Стрес. Не бива да подценяваме психическото влияние на процедурата върху нас. Финансовата страна на инвитро може да е причина за допълнителен стрес, както и самата сложност на процедурата и големия брой тестове, изследвания и процедури, на които ще бъдем подложени. Погрижете се добре за собственото си психично здраве, както и за спокойствието на партньора си.
- Усложнения при вземане на яйцеклетки. По време на началните етапи на инвитро се използва дълга игла, която извлича нужните яйцеклетки. По време на тази процедура и след нея може да изпитаме кървене, болка и дискомфорт. Възможно е да получим определени нежелани ефекти, представляващи реакция на организма към използваната упойка.
- Странични ефекти при стимулиране на яйчниците. Преди да се вземат нужните яйцеклетки, бъдещите майки приемат определени медикаменти, които стимулират овулацията и производството на готови за оплождане яйцеклетки. Наблюдават се странични ефекти като подуване на стомаха, повръщане, болка и дискомфорт.
- Усложнения с плода. Процентът на ранен спонтанен аборт и дефекти в плода се равняват на вероятността при майки, заченали естествено. Въпреки това трябва да сме наясно с рисковете на бременността преди инвитро процедурите и докато те траят.
Инвитро процедурите носят някои нежелани ефекти, които до определена степен можем да намалим, за да сме спокойни за бъдещата си бременност.
Колко струва инвитро?
Цената на инвитро процедурите варира спрямо много фактори като броя на процедурите, нужните изследвания, както и спецификите на индивидуалното здраве на жената и мъжа. Препоръчва се да се консултирате с клиника, която практикува този тип изкуствено оплождане, за да получите точна информация за личния си случай.
Заключение

Инвитро е един от начините да забременеем, ако не можем да го направим по естествен път. Те включват различни изследвания и процедури, с които може да ни запознае лекар, преди да тръгнем по този път. Това е медицински начин да имаме дете, като се използва генетичен материал и от двамата родители.
Често задавани въпроси
Какво представлява инвитро оплождането?
Това е поредица от сложни процедури, които целят оплождане на яйцеклетка и бременност. Инвитро се използва от жени, при които не може да се получи естествено оплождане. В някои случаи може да се използва тази процедура, за да се избегне предаване на генетични заболявания на децата.
Защо се прави инвитро оплождане?
Инвитро често се използва от двойки, при които жената е над 40-годишна възраст. Среща се обаче и при различни здравословни причини, които може да направят естественото зачеване трудно или невъзможно.
Може ли да се появят усложнения?
Възможно е да се появят определени нежелани ефекти вследствие на процедурите. Стресът е най-често срещаното усложнение от процедурата. Освен него обаче има и някои рискове по време на самите процедури, с които лекарите ще ни запознаят.
Колко струва инвитро?
Цената на инвитро процедурите варира спрямо много фактори като броя на процедурите, нужните изследвания, както и спецификите на индивидуалното здраве на жената и мъжа. Препоръчва се да се консултирате с клиника, която практикува този тип изкуствено оплождане, за да получите точна информация за личния си случай.
Източници
Блог
Рецепти
Популярни продукти
Свързани публикации
Въпреки че замразяване на яйцеклетки вече не е чужда концепция, не всеки е наясно с пълния процес, който
Ако планирате зачеване, има няколко важни стъпки преди забременяване, които е добре да спазите.
Всяка жена научава много нова информация от момента, в който реши да има дете, до раждането и дори









